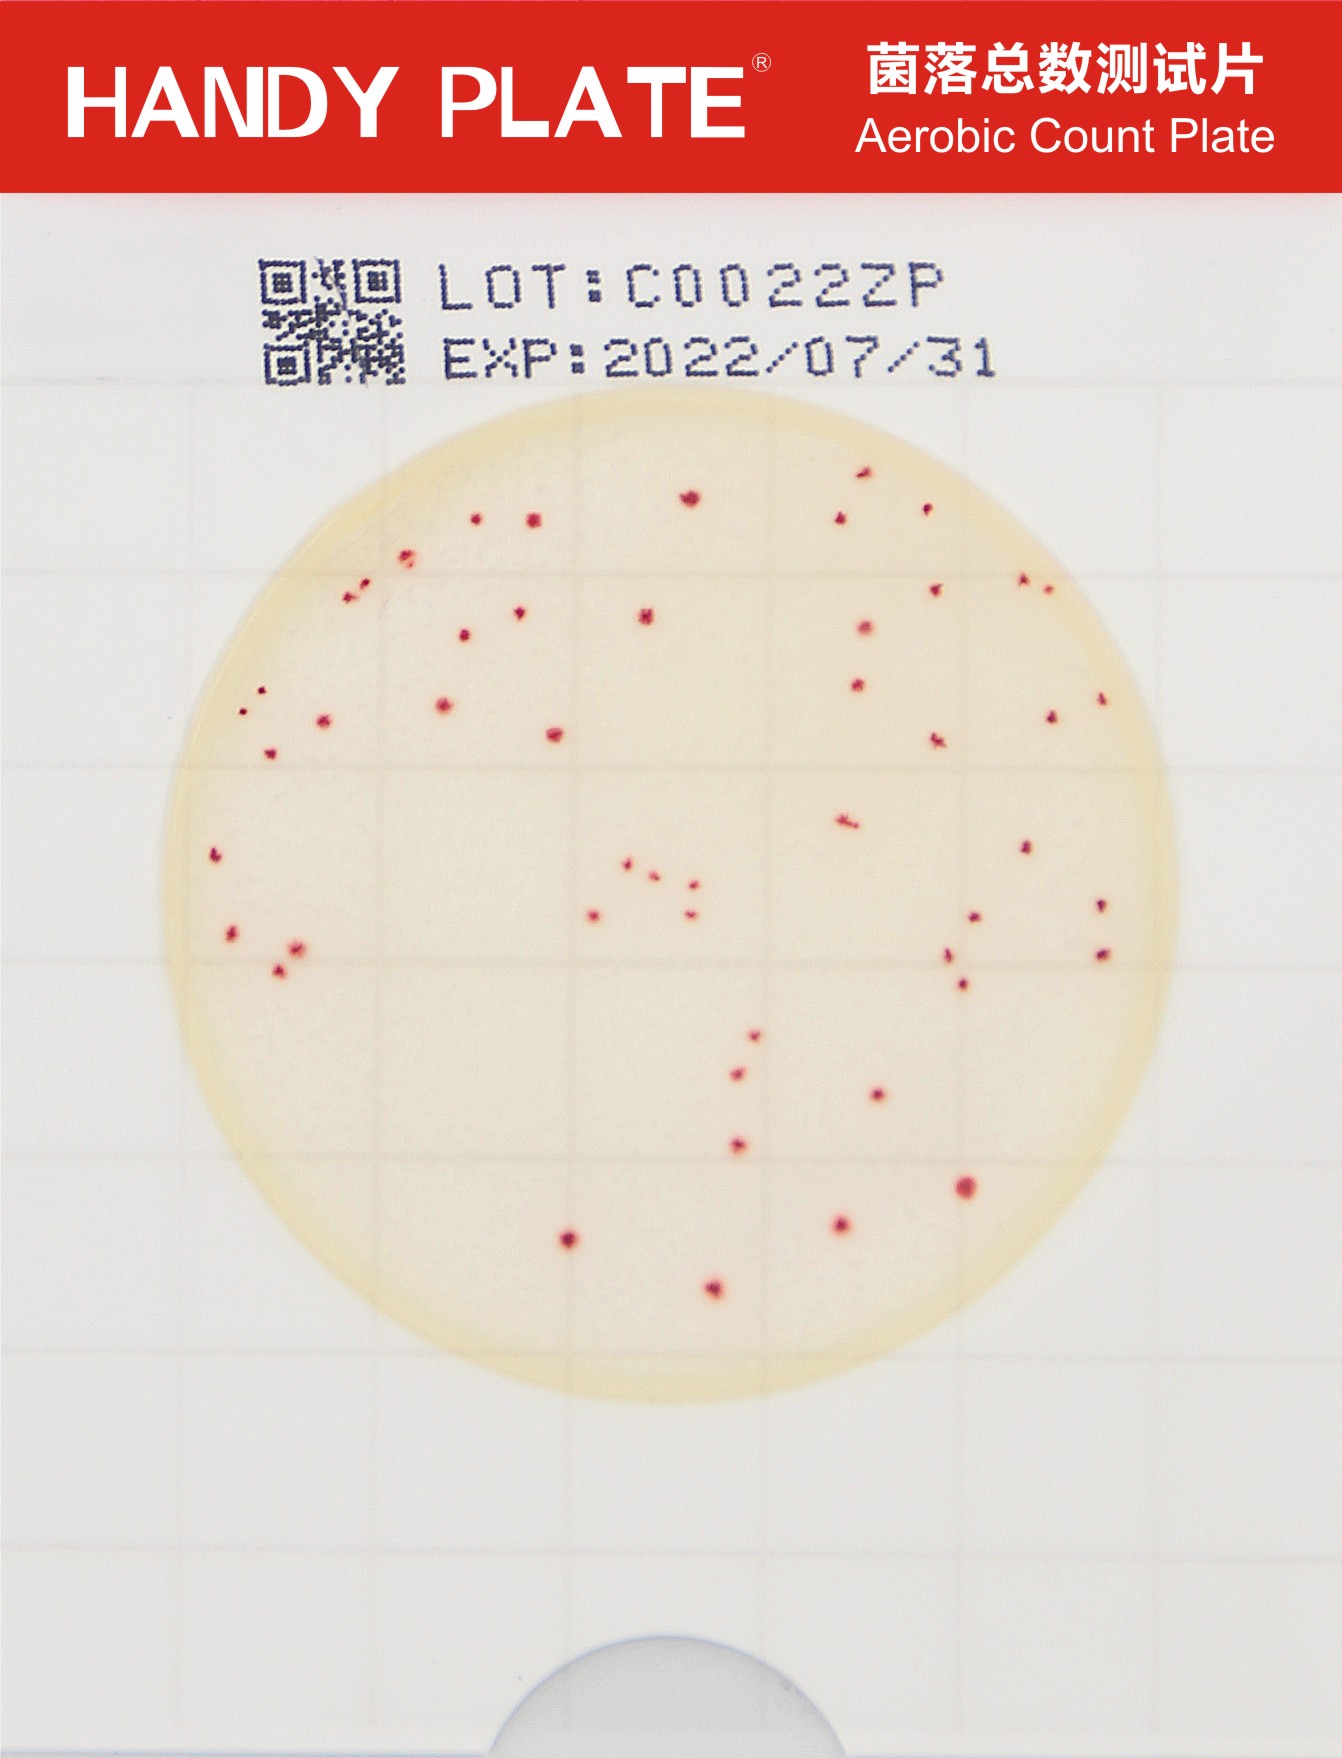
菌落总数测试片
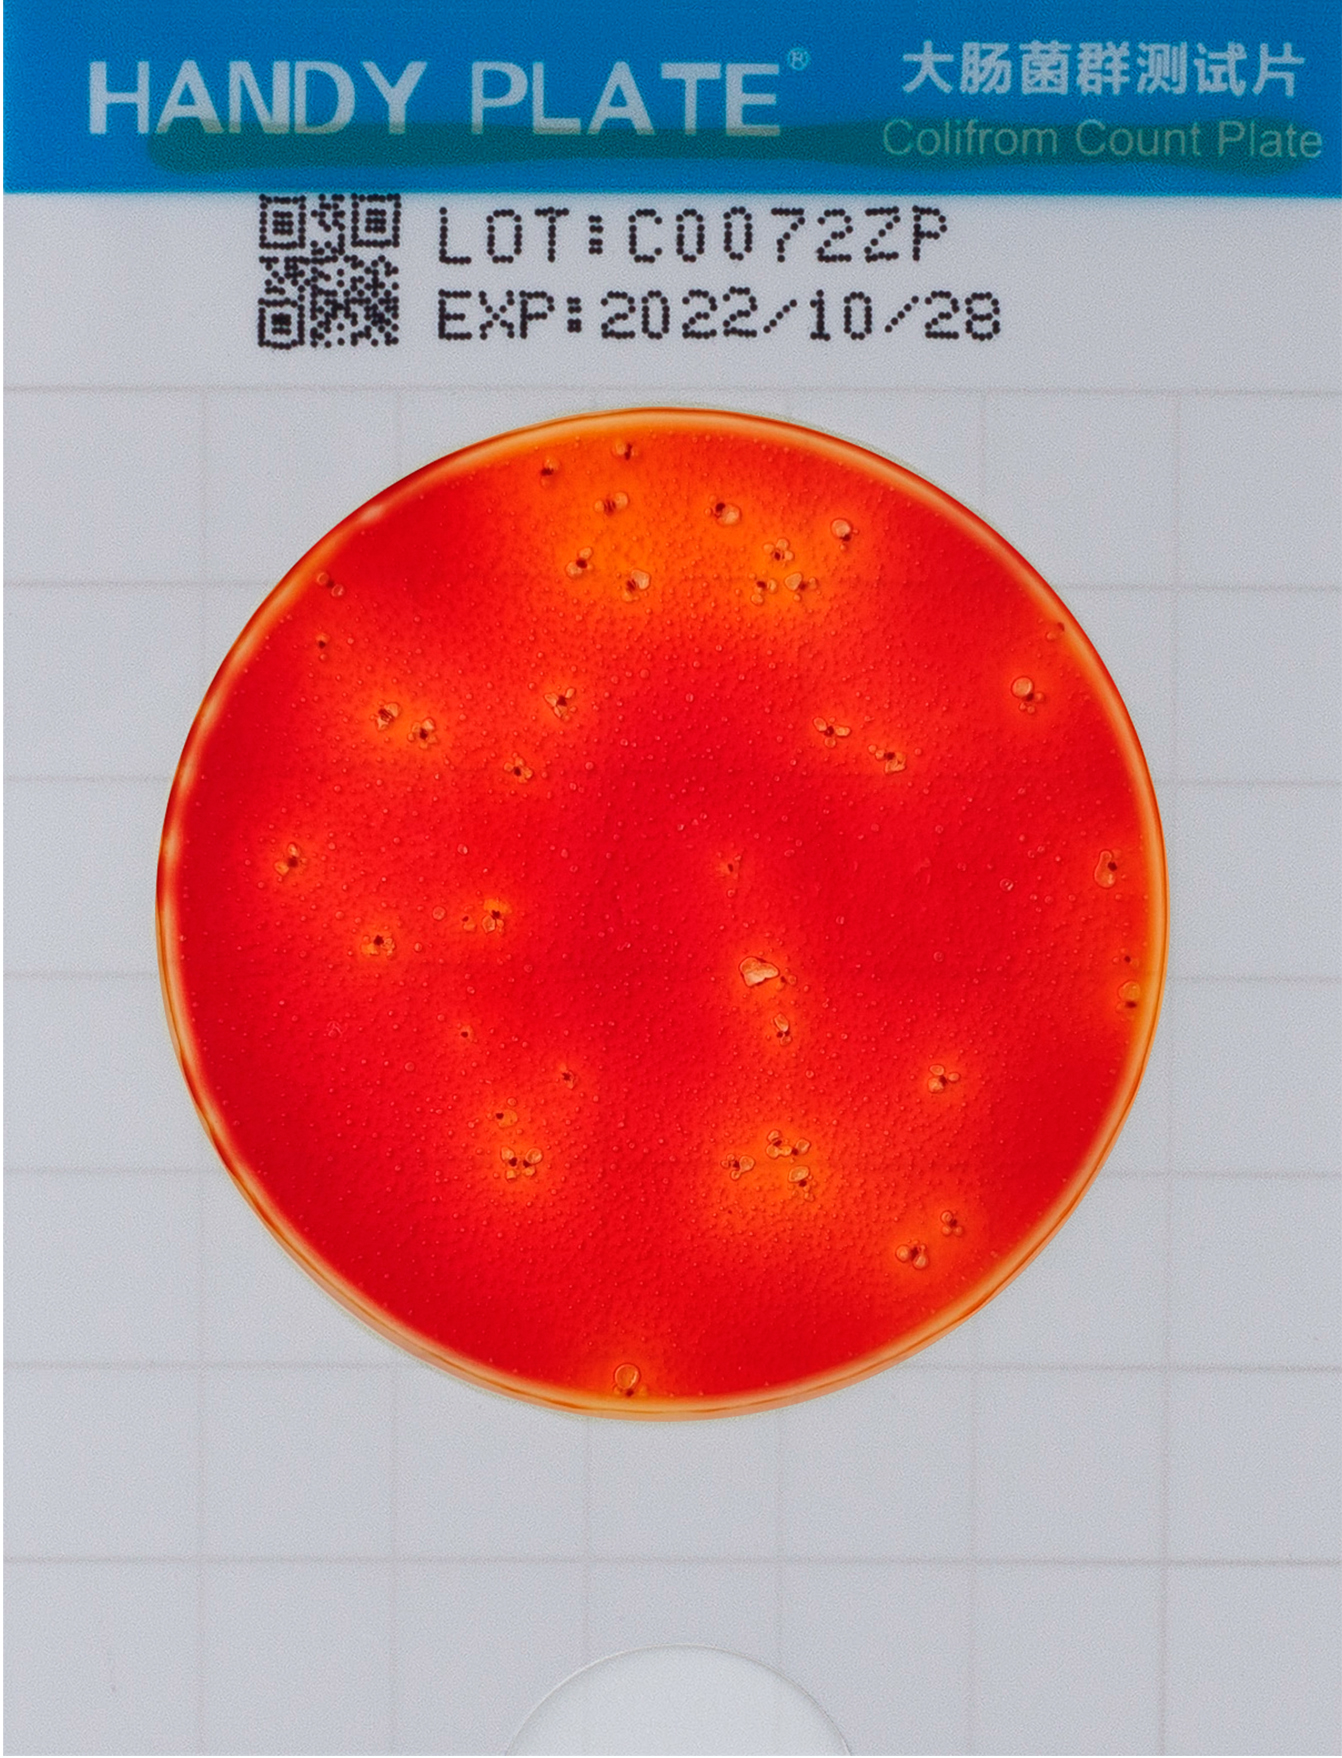
大肠菌群测试片
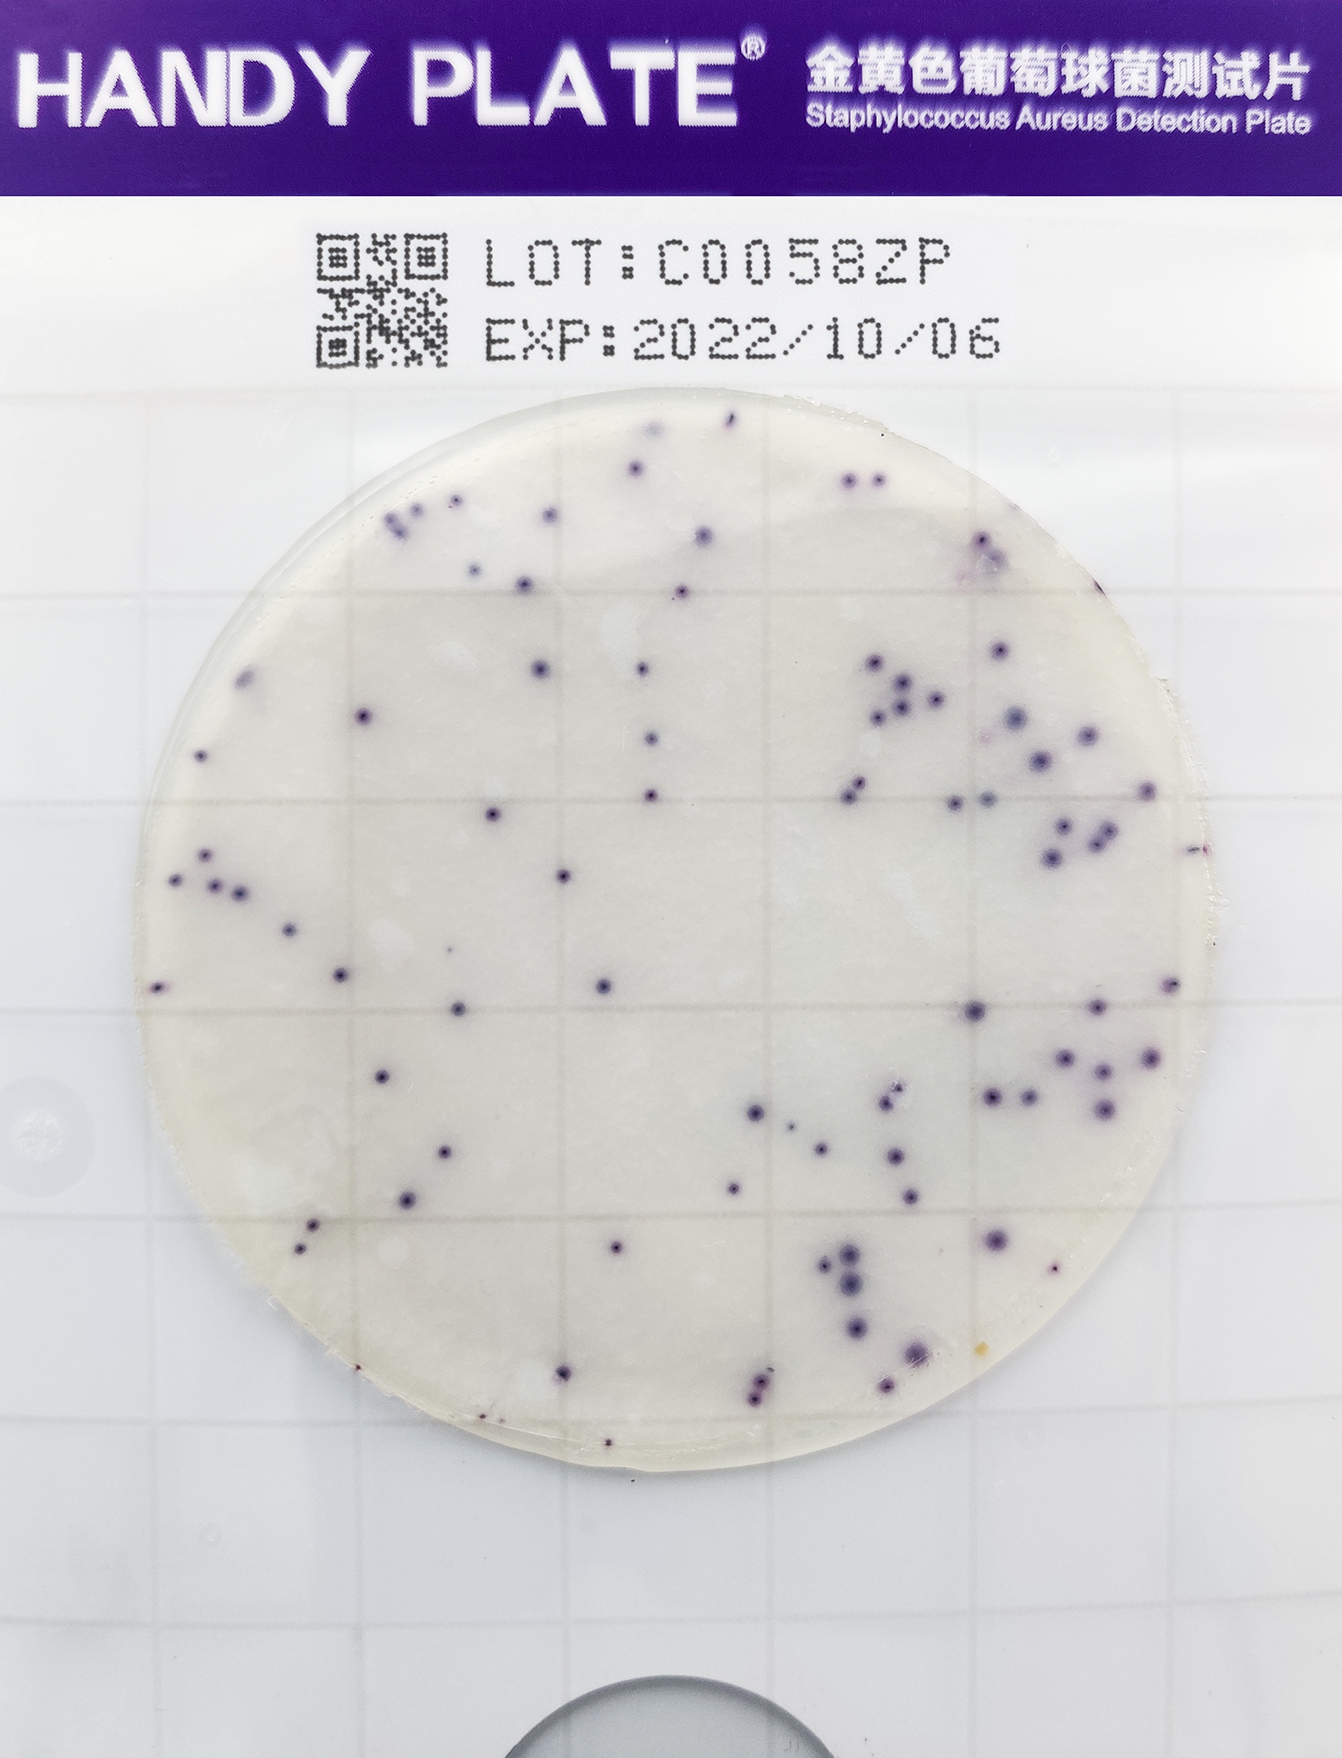
⾦⻩⾊葡萄球菌测试⽚
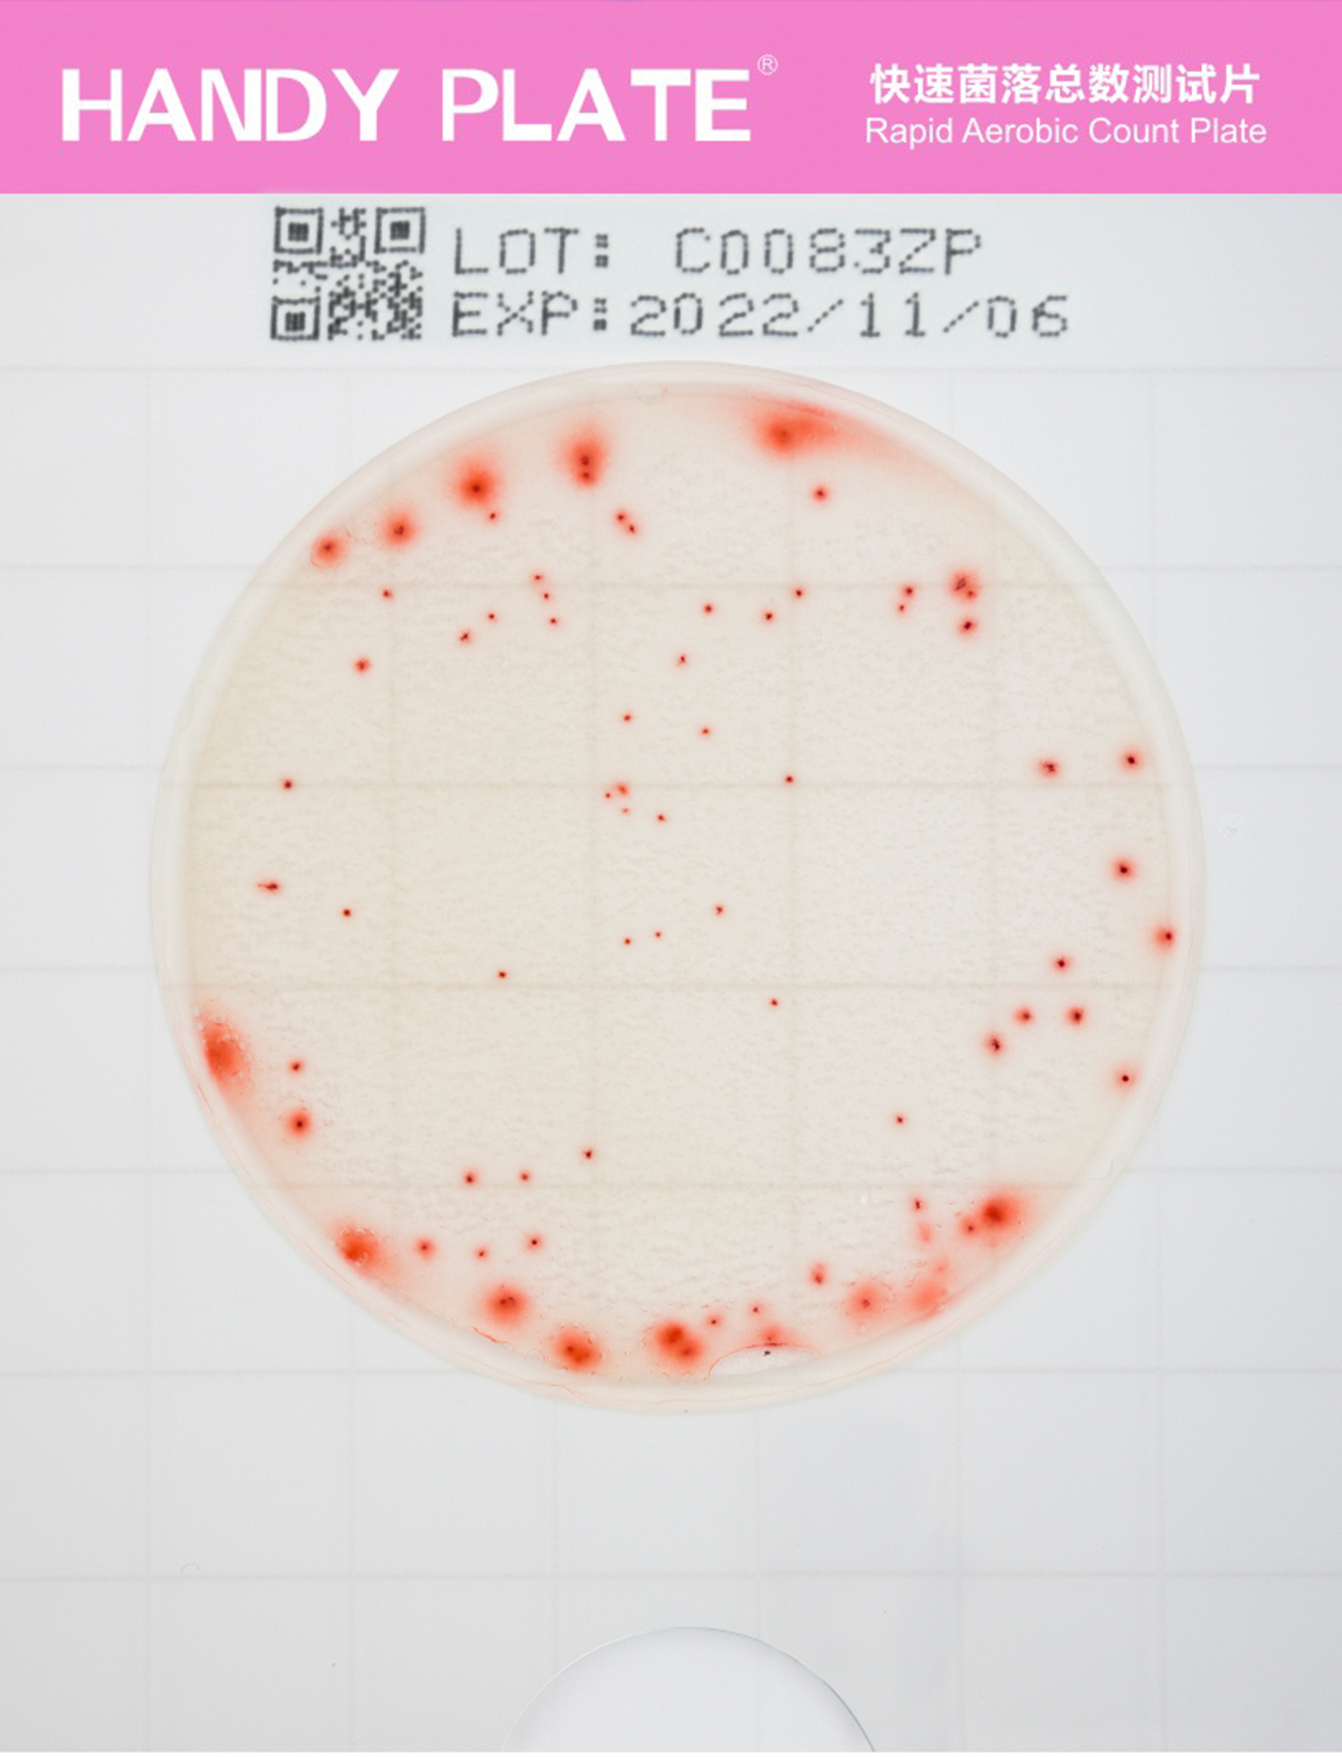
快速菌落总数测试⽚

HANDY PLATE®系列微⽣物测试⽚是传统培养基的升级替代产品,具有即开即⽤ 、省时 省地、操作简单、结果可靠的特点!
HANDY PLATE®系列微⽣物测试⽚由轻便防⽔纸质材料做⽀撑,其上覆盖⼲燥培养基层 (营养物质、凝固剂、选择抑制剂、显⾊剂)和透明隔⽔膜,经辐照灭菌。培养基层可吸收1mL样 液形成凝胶层,微⽣物⽣⻓代谢产⽣的酶⽔解显⾊剂从⽽使菌落显⾊。
该系列产品包含卫⽣指⽰菌和致病菌测试⽚,可⼴泛⽤于⻝品、饮料等微⽣物检测,涵盖 ⽣产原料、终产品和⽣产环境中卫⽣指⽰菌(菌落总数、⼤肠菌群、霉菌酵⺟)和致病菌(沙⻔ ⽒菌、⾦⻩⾊葡萄球菌、阪崎克罗诺杆菌等)快速检测。
符合⼈体⼯学,加样⽆需压板,专为简便操作⽽设计
| ● 测试⽚覆盖透明⽹格薄膜,⽅便观察和标记样品信息; ● 每个测试⽚拥有唯⼀编码,便于追踪溯源; ● 中间为圆形⼲制⽆菌标准培养基和琼脂样凝胶,免配置; ● 培养基周围具有凸起胶圈,可防⽌样液外溢; ● 底部设计半⽉形缺⼝,⽅便揭膜; | ![]() |
![]() | |
产品优势
24⼩时快速菌落总数 48⼩时快速霉菌酵⺟计数
结果准确 ⾼性能显⾊培养基,结果准确可靠; 菌落规则 琼脂样凝胶,相对于⽆纺布式纸⽚,菌落排列更规则; 简单易⽤ 轻便设计,开袋即⽤,储运和使⽤更便捷; 经济环保 ⽆粉尘,体积⼩,重量轻,更经济环保; 保质期⻓ ⼲制⽆⽔培养基,经辐照灭菌,性能稳定,保质期更⻓; 不易液化 芽孢杆菌等⽆液化扩散现象,更易于观察计数; 不易扩散 控制霉菌菌丝扩散,菌落更集中,显⾊更明显 | ![]() |
使⽤⽅法
只需3步,即可实现快速准确的测定!
结果可靠,经验证与国家标准⽅法拟合度良好
| 纯菌(右键“在新标签页中打开图片”可查看高清大图!) | ||||||||
|---|---|---|---|---|---|---|---|---|
|
|
| ||||||
| 样品(⼈⼯污染和⾃然污染)(右键“在新标签页中打开图片”可查看高清大图!) | ||||||||
|
|
| ||||||
|
|
| ||||||
HANDY PLATE®系列微⽣物测试⽚ 产品信息
| 产品名称 | 货号 | ⽤途 | 规格 | 储存 | 保质期 |
| 菌落总数测试⽚ | HP001 | 菌落总数计数 | 20⽚/包 | 2~8℃ | 18个⽉ |
| 快速菌落总数测试⽚ | HP011 | 菌落总数快速计数 | 20⽚/包 | 2~8℃ | 18个⽉ |
| ⼤肠菌群测试⽚ | HP002 | ⼤肠菌群计数 | 20⽚/包 | 2~8℃ | 18个⽉ |
| 霉菌酵⺟测试⽚ | HP003 | 霉菌酵⺟计数 | 20⽚/包 | 2~8℃ | 18个⽉ |
| 快速霉菌酵⺟测试⽚ | HP012 | 霉菌酵⺟快速计数 | 20⽚/包 | 2~8℃ | 18个⽉ |
| ⼤肠杆菌/⼤肠菌群测试⽚ | HP004 | ⼤肠杆菌/⼤肠菌群检测 | 20⽚/包 | 2~8℃ | 18个⽉ |
| 沙⻔⽒菌测试⽚ | HP005 | 沙⻔⽒菌检测 | 20⽚/包 | 2~8℃ | 18个⽉ |
| 沙⻔快速增菌培养基 | HP005E | 沙⻔⽒菌测试⽚检测⽤样品的沙⻔⽒菌的增菌培养 | 250g/瓶 | 2-25℃ | 3年 |
| 阪崎克罗诺杆菌测试⽚ | HP006 | 阪崎克罗诺杆菌检测 | 20⽚/包 | 2~8℃ | 18个⽉ |
| ⾦⻩⾊葡萄球菌测试⽚ | HP007 | ⾦⻩⾊葡萄球菌检测 | 20⽚/包 | 2~8℃ | 18个⽉ |
| 单增李斯特⽒菌测试⽚ | HP008 | 单增李斯特⽒菌检测 | 20⽚/包 | 2~8℃ | 18个⽉ |